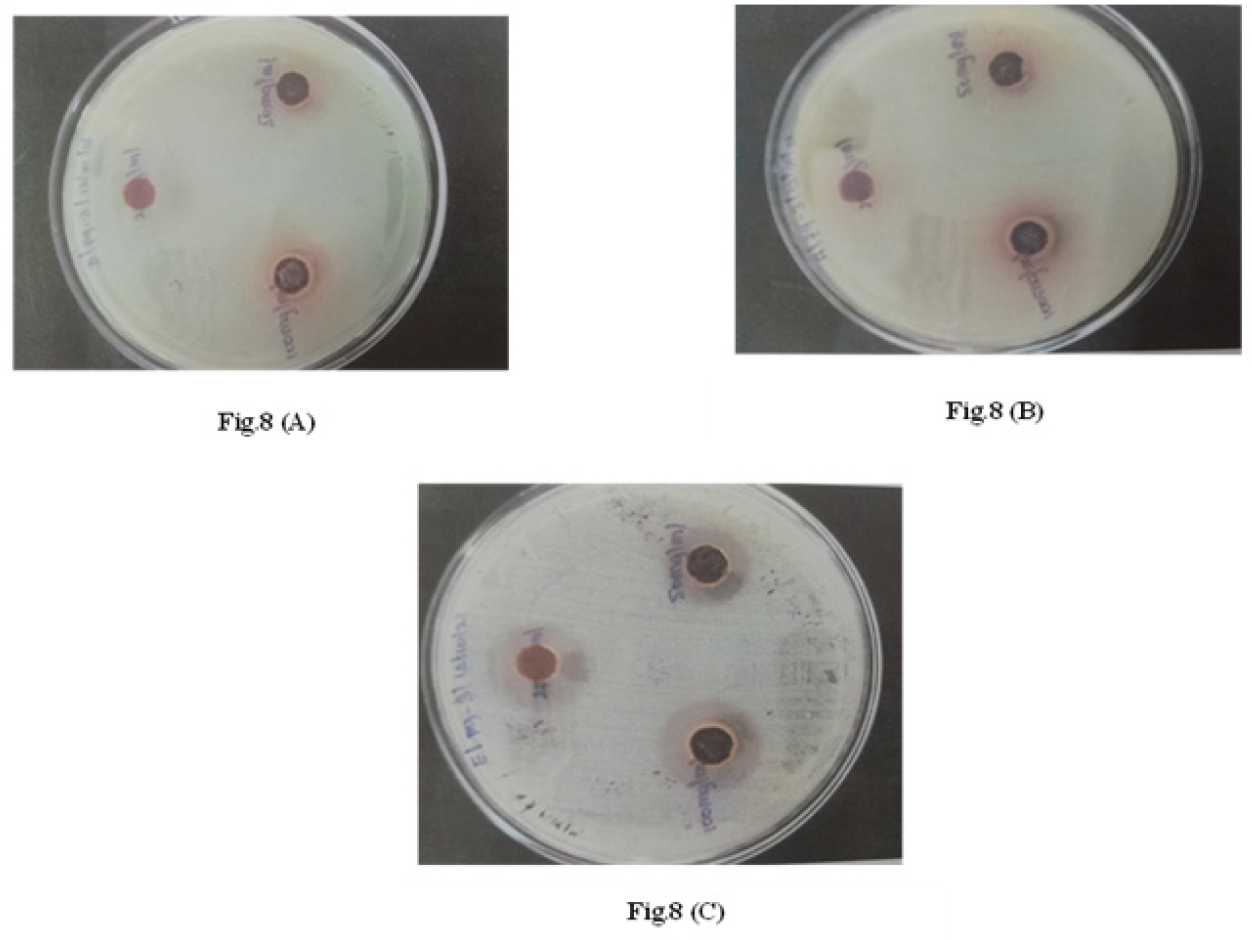

ABSTRACT
Background
Pyrazoline derivatives have significant medicinal use for their diverse pharmacological activities. Zebrafish embryos are mostly used in toxicity studies due to its transparency, rapid development and genetic similarity to humans. Fish Embryo Toxicity Test provides rapid, ethical and resource efficient screening. This study aimed to synthesize and evaluate a novel pyrazoline derivative for antibacterial, cytotoxic, and toxicity properties.
Materials and Methods
The compound 3-(1,3-diphenyl-4,5-dihydro-1H-pyrazole-5-yl)-2-methoxyphenol, was synthesized through a multi-step Mannich reaction and characterized using FT-IR, NMR and Mass spectrometry. Drug likeness and pharmacokinetic parameters were predicted with Molinspiration, OSIRIS, and SwissADME software’s. Molecular docking targeted Topoisomerase II and DNA gyrase. Antibacterial activity was tested against E. coli, P. aeruginosa and S. aureus. Cytotoxicity effect against Dalton’s Lymphoma Ascites cells and Zebrafish Embryo Toxicity (OECD 236) was evaluated for its toxicity.
Results
Computational prediction shows favourable drug-likeness and adherence to Lipinski’s five rules. Docking studies demonstrated substantial binding affinities: -8.14 kcal/mol and -7.28 kcal/mol for Topoisomerase II and DNA gyrase respectively. The compound exhibited potent anti-bacterial activity with inhibition zone ranging from 12 to 17 mm at 100 µg/mL. Cytotoxicity assay revealed dose-dependent increase in cell death, reaching 86.3±2.0% at 200 µg/mL. Zebrafish embryo toxicity assay revealed developmental abnormalities at 50 µg/mL and 25 µg/mL, with an LC50 of 18.75 µg/mL.
Conclusion
The compound exhibited favourable pharmacokinetic properties, suggesting its potential as an antibacterial and cytotoxic agent. However, Zebrafish Embryo toxicity highlights the need for further development and in-depth evaluation before it can as a therapeutic candidate.
INTRODUCTION
Pyrazoline derivatives are a class of compound of great interest due to their diverse biological properties and pharmacological activity. Their unique properties make them highly valuable in drug design and development, while their broad synthetic versatility extends their applications across pharmaceuticals, agrochemicals, and materials science (Turkanet al., 2019; Kumaret al., 2009). They exhibit pharmacological properties, including anti-bacterial, anti-microbial, anti-cancer, CNS activity, anti-inflammatory, antioxidant, anti-tubercular, anti-viral, anti-hyperglycaemia, anti-convulsant and anti-depressant activity (Nehraet al., 2020; Ravindaret al., 2023; Songet al., 2020a). Spectroscopic techniques such as FT-IR, ¹H NMR, ¹³C NMR, and Mass spectrometry provide rapid and reliable characterization of chemical compounds (Miret al., 2020). Molecular docking is a well-established in silico structure-based approach used in early-stage drug development to identify the new therapeutic compounds, predict ligand-target interaction at molecular level and understand the structure-activity relationship (Pinzi and Rastelli, 2019; Ferreiraet al., 2015a). Bactericidal agents eliminate pathogenic bacteria and may help reduce bacterial plaque in the environment. However, not all antibacterial agents possess specific anti-plaque properties. The production and utilization of antibacterial biomaterials in medicine are advancing in various implants, restorative materials, denture-based materials, and tissue conditioners with antibacterial properties were being manufactured and marketed (Kaur and Liu, 2016; Kharaevaet al., 2020). Cytotoxicity refers to the harmful effects a substance can have on cells and is a key measure for evaluating the safety of drugs and therapies. Cytotoxicity assessment plays a critical role in cancer treatment, immunology, toxicology, and materials research by ensuring the safety and guiding the risk assessment of novel compounds (Risset al., 2019).
Zebrafish (Danio rerio) is a widely used model for toxicity screening due to their transparency, rapid development and genetic similarity to humans. Fish embryos are valuable in toxicity studies owing to their sensitivity towards environmental changes (Rawlingset al., 2019). Fish Embryo Toxicity (FET) test offers an efficient alternative to traditional animal testing, providing rapid results, reduced resource consumption, and aligning with ethical considerations for early-stage toxicity screening (Braunbecket al., 2015) (Test No. 236: Fish Embryo Acute Toxicity (FET) Test, 2013). The FET test is primarily used to determine the Lethal Concentration (LC₅₀) of a compound, and asses its effects on fish embryos to evaluate potential environmental and health risks. It is increasingly recommended as an alternative to Acute Fish Toxicity tests (AFT), particularly when AFT limit tests indicate toxicity. Comparison studies have demonstrated a strong correlation between FET and AFT outcomes, with a meta-analysis suggesting that narcotic substances exhibit comparable sensitivity in both tests. The main differences are attributed to species variability in AFT (Rawlingset al., 2019; Danget al., 2017; Birke and Scholz, 2019). The FET test is now a mandatory component of ecotoxicity testing requirements and is widely endorsed for developing toxicological profiles of chemical derivatives (Birke and Scholz, 2019; Fekaduet al., 2022). Importantly, using only embryos, eliminating the need to sacrifice adult fish, which aligning with ethical considerations (Danget al., 2017). The current study evaluates both the therapeutic efficacy and toxicity profile of the molecule to establish its safety before preclinical studies. The in silico and in vitro screening, along with the use of zebrafish as an alternative model organism, provides insights into the safety, biological efficacy, and developmental toxicity of the novel synthesized compound (Braunbecket al., 2015; Test No. 236: Fish Embryo Acute Toxicity (FET) Test, 2013). In this study, a novel pyrazoline derivative, 3-(1,3-diphenyl-4,5-dihydro-1H-pyrazole-5-yl)-2-methoxyphenol, was synthesized and structurally characterized by spectroscopy studies. Its antibacterial and cytotoxic activities were assessed through in vitro assays, while its toxicity profile was evaluated through LC₅₀ determination using the Zebra FET assay as per OECD Guideline 236. Molecular docking and Qualitative Structural Activity Relationship (QSAR) analyses were undertaken to investigate the compound’s binding affinity toward key enzymes such as DNA gyrase and Topoisomerase II, providing meaningful insights into its predicted biological activity.
MATERIALS AND METHODS
Reagents
Analytical grade chemicals (HPLC grade): Vanillin, Acetophenone, Aniline, Guanidine Hydrochloride, Acetone, Ethanol, Hydroxylamine Hydrochloride, 40% NaOH Solution from India Mart and Yarrow Chem Products were purchased and used without any further purification.
Chemistry
A β-amino carbonyl intermediate was synthesized via a Mannich-type condensation of aromatic ketones, vanillin, and aniline using guanidine hydrochloride under solvent-free conditions with stirring at room temperature. The crude product was then purified by recrystallization. Subsequently, this intermediate was reacted with hydroxylamine hydrochloride in ethanol, with 40% NaOH added dropwise, and refluxed for 4 hr. Following workup, the target pyrazoline derivative, 3-(1,3-Diphenyl-4,5-dihydro-1H-pyrazole-5-yl)-2-methoxyphenol, was obtained. Analytical TLC was performed on pre-coated sheets of silica gel G/UV-254 of 0.2 mm thickness using analytical grade solvent and visualizes with UV Light (Songet al., 2020a).
Materials
Preliminary QSAR study was performed to identify the structural relationships between chemical and biological properties of a compound by using Molinspiration (Khanet al., 2017). Toxicity was assessed for the synthesized compound using OSIRIS software (Mohammedet al., 2022; Rajalakshmiet al., 2021; Kambojet al., 2023). ADME properties were also determined to explore the pharmacokinetic properties by using Swiss ADME software (Fekaduet al., 2022; Dainaet al., 2017). The compound’s melting point was assessed using a capillary method with the aid of a melting point determination apparatus. IR spectra were determined by KBr pellet method with FT-IR and 1HNMR and 13CNMR spectra were acquired on a Bruker 500 MHz spectrometer, while mass spectra were recorded using mass spectrometry (Moraleset al., 2024; Cerecedo-Sáenzet al., 2022; Avramet al., 2021). The synthesized compound was docked on the target protein by using Auto Dock version 4.2 against target protein molecules for toxicity (Araujo-Limaet al., 2023; Cerecedo-Sáenzet al., 2022). The compound was screened for anti-bacterial activity using Agar well diffusion method that measures the Inhibition Zone (IZ) in mm. Further, the compound was assessed by studied for the short-term In vitro cytotoxicity test against Dalton’s Lymphoma Ascites (DLA) cells to determine the cell viability (Jędrzejczyk etal., 2022; Liet al., 2015). Lethal Dose (LC50) for the test compound was determined by Fish Embryo Toxicity (FET) Test performed on Zebrafish as the model organism.
Synthesis
The novel pyrazoline derivative was synthesized using a multi-step Mannich reaction starting from a β-amino carbonyl compound. A mixture of aromatic ketones (2.2 mmol), vanillin (2.0 mmol), and aniline (2.0 mmol) was treated with guanidine hydrochloride (10 mol%) under solvent-free conditions at room temperature. The reaction mixture was stirred for 4 hr with the help of magnetic stirrer, and the precipitated solid was collected by filtration. The solid was washed with water to remove any unreacted guanidine hydrochloride, which was soluble in water. The crude product was then purified by recrystallization from a mixture of acetone and ethanol in the ratio (2:3) to obtain the pure intermediate compound which was mentioned in the scheme.
In the next step, the purified intermediate compound was dissolved in (10 mL) ethanol along with 0.05 mol of hydroxylamine hydrochloride. A 40% NaOH solution was added dropwise with constant stirring. The reaction was maintained under reflux conditions on a water bath for 4 hr, and its completion was monitored by TLC using hexane: ethyl acetate (7:3) solvent system. After the reaction was complete, the mixture was allowed to cool to room temperature and then poured into ice-cold water. The resulting precipitate was neutralized with N/10 HCl, filtered, and dried to yield the desired product, 3-(1, 3-Diphenyl-4, 5-dihydro-1H-pyrazole-5-yl)-2-methoxyphenol.
In silico QSAR, Toxicological and ADME Properties
A preliminary QSAR analysis was conducted using Molinspiration software to explore the structural relationship between the compound’s chemical features and its biological activity, as well as to evaluate compliance with Lipinski’s rule of five (Araujo-Limaet al., 2023). Toxicity predictions for the synthesized compound were assessed using OSIRIS software (Mohammedet al., 2022; Rajalakshmiet al., 2021). Additionally, the compound’s structure was converted into its Simplified Molecular-Input Line-Entry System (SMILES) format and submitted to the Swiss ADME tool (Moraleset al., 2024) to estimate in silico pharmacokinetic parameters and other molecular properties.
Characterization
The synthesized novel pyrazoline compound, 3-(1,3-Diphenyl-4,5-dihydro-1H-pyrazole-5-yl)-2-methoxyphenol was characterized using a range of analytical techniques. Its melting point was determined using a capillary method with a standard melting point apparatus. Fourier-Transform Infrared (FT-IR) spectroscopy, performed using the KBr pellet method, was employed to identify the functional groups present in the compound (Fekaduet al., 2022; Moraleset al., 2024; Cerecedo-Sáenzet al., 2022; Avramet al., 2021). Nuclear magnetic resonance analysis, including both ¹H NMR and ¹³C NMR, was performed on a high-resolution Bruker 500 MHz spectrometer to elucidate the structural features of the synthesized compound (Breindelet al., 2019). Furthermore, mass spectrometry was employed to determine the molecular weight and fragmentation pattern of the target molecule (Bouillon, 2016).
Docking Study
The binding interaction of the obtained pyrazoline derivative to DNA Gyrase (PDB Id-5MMO) and Topoisomerase II (PBD Id-1ZXM) enzymes were evaluated by in silico docking studies. Three-dimensional structures of the enzymes were obtained from RCSB protein data bank repository, stripped of any bound ligand and used as rigid structure for docking. The proteins were then prepared for molecular docking by removing any heteroatoms and addition of hydrogen atoms once water molecules were removed. Topoisomerase II (1ZXM) and DNA gyrase (5MMO) were prepared for molecular docking by identifying their active binding sites using the PDB sum database (Songet al., 2020). This enabled the selection of the most suitable binding pockets for ligand interaction, ensuring accurate docking simulations. The identified active sites for Topoisomerase II and DNA gyrase are illustrated in Figures 1(A) and 1(B). This comprehensive in silico approach has enabled us to thoroughly evaluate the potential interactions with compound. For the preparation of ligand molecule, its two-dimensional structure was prepared in a pdb file format using Marvin Sketch program (Rajalakshmiet al., 2021; Ibrahimet al., 2021). The receptor grid was positioned at 60Å to encircle the target’s region of interest. The optimal docked configuration between the protein and the ligand was obtained using the docking program Autodock 4.2. A sequence of 25 genetic algorithm runs were necessary to obtain the appropriate docking configuration. The analysis procedure, supported by the conformation procedure and Root Mean Square Deviation (RMSD), was carried out to determine the docking score, inhibition constant and ligand efficiency value based on the interaction between the protein and ligand molecules, culminating in the production of a table in the dlg file (Fekaduet al., 2022; Ibrahimet al., 2021). Discovery Studio Visualizer was used to analyse the interactions among the target receptor and ligands in the conformations with the most advantageous (least) free binding energy. In the line and stick model depiction, ligands are represented as balls and sticks, proteins as ribbons, and H-bonds and interacting residues as lines and sticks. 2D interaction diagrams were generated to visualize significant molecular interactions including hydrogen bonding, hydrophobic interactions and π-π stacking between the ligand and the receptor. 2D interaction maps helped provide a detailed representation of the binding pocket enabling identification of key residues involved in ligand binding(Fekaduet al., 2022; Ferreira et al., 2015b).

Figure 1:
2D depiction of the active binding pocket of target enzymes (A) Topoisomerase II, and (B) DNA gyrase. Interacting ligands are shown in ball and stick representation.
In vitro anti-bacterial assay
The synthesised derivative was evaluated for anti-bacterial activity using Agar well diffusion method to measure the extent of the Inhibition Zone (IC50) (Boyanovaet al., 2005a). Three standard bacterial strains, two Gram negative (Escherichia coli MTCC- 443 and Pseudomonas aeruginosa MTCC-424) and one Gram positive bacteria (Staphylococcus aureus MTCC-96) were used. The result was compared with Ciprofloxacin (70 µg/mL) as a standard drug. Antibacterial Activity (Agar Well Diffusion Method)- Mueller-Hinton Agar (MHA) was prepared using beef infusion (300 g), acid hydrolysate of casein (17.5 g), starch (1.5 g), agar (17 g), and distilled water (1 L). The mixture was heated until agar dissolved and sterilized at 121ºC, 15 psi for 15 min, and then poured into sterile Petri dishes under aseptic conditions. Wells (10 mm) were created using a sterile cork borer (Boyanova et al., 2005b). The antibacterial activity was tested against three common standard bacterial strains including two Gram negative and one Gram positive bacteria. Bacterial inoculums were prepared from 18-24-hr cultures and adjusted to standard turbidity. A sterile swab was used to evenly spread the inoculum onto MHA plates. The test solution (Synthesized compound) was prepared by dissolving 1 mg of the compound in 1 mL of Dimethyl Sulfoxide (DMSO). Each well was filled with 70 µL of test solutions (10 µg/µL) with varying concentration such as 10, 25 and 50 µg/mL. Plates were incubated at 37ºC for 24 and 48 hr, and the Zone of Inhibition (IZ) was measured. Ciprofloxacin (70 µg/mL) was used as the standard (Fekaduet al., 2022; Jędrzejczyket al., 2022; Liet al., 2015).
In vitro cytotoxicity assay
The test compound was subjected to short-term In vitro cytotoxicity assay using Dalton’s Lymphoma Ascites (DLA) cells. Cell Viability of the test compound was determined by Trypan blue exclusion method. The test compound was provided to Amla Cancer Research Institute (Trissur) to perform the short term – cytotoxicity assay. The method is as follows; Phosphate-Buffered Saline (PBS) was used three times to wash the tumor cells removed from the peritoneal cavity of mice. A viable cell suspension (1*106 cells in 0.1 mL) was prepared and added into the tubes containing varying concentrations of the test chemical. The final volume in each tube was standardized to 1 mL using PBS. A control tube containing only the cell suspension, without the test compound, was included. The mixtures were then incubated at 37ºC for 3 hr. Following the incubation period, 0.1 mL of 1% trypan blue dye was added to each tube and allowed to stand for 2-3 min after mixing thoroughly. The cell sample suspension was subsequently loaded onto a hemocytometer, and both the stained (Dead cells) and unstained (Live) cells were counted separately. The percentage of viable cells was calculated using the following formula: (Fekaduet al., 2022;Yanget al., 2020).
Fish Embryo Toxicity (FET) Test
The fish embryo acute toxicity test was conducted following OECD Test Guideline 236 (OECD, 2013). Adult Zebrafish were maintained in a conditioned tank water system under a 14-10 hr’ light dark cycle at 28ºC. Zebrafish were kept in the breeding chamber and embryos obtained were maintained in Petri dishes containing Reverse Osmosis water or E3 medium. Fertilized embryos were transparent and separated from the unfertilized embryos which look opaque. Visible embryos were rinsed in E3 medium thrice and then were subjected to toxicological analysis. Stock solutions of each synthesized compound were prepared in 1% acetone, followed by serial dilutions to obtain the desired working concentrations. The test solutions were prepared in 1% acetone at final concentrations of 200 µg/mL, 100 µg/mL, 50 µg/mL, 25 µg/mL, and 12.5 µg/mL. Zebrafish embryos at the 4-hr post-fertilization (hpf) stage were distributed into 24-well plates (12 embryos / well). The plates were incubated at 28ºC, and embryo mortality, hatching rate, and developmental abnormalities were observed at 24, 48, 72, and 96 hr, post-exposure (Test No. 236: Fish Embryo Acute Toxicity (FET) Test, 2013). Embryo morphology was assessed and scored based on the degree of toxicity, with a scale ranging from 5 (non-toxic) to 0.5 (highly toxic). Statistical analysis of the toxicity scores was performed using GraphPad Prism software, employing two-way ANOVA for comparison (Test No. 236: Fish Embryo Acute Toxicity (FET) Test, 2013) (Sobanskaet al., 2018; Baueret al., 2021). The teratogenic scoring data were analysed against the positive control, 3,4-Dichloroaniline (DCA). The lethal concentration values, such as LC50, were calculated using probit analysis (Test No. 236: Fish Embryo Acute Toxicity (FET) Test, 2013).
RESULTS
Synthesis of Test Compound
The synthesis of 3-(2-methoxyphenyl)-1,3-diphenyl-4,5-dihydro-1H-pyrazole was achieved through a multi-step reaction sequence using vanillin, acetophenone, and aniline as starting materials. The reaction scheme is illustrated in Figure 2. The first step involved the reaction of vanillin with acetophenone and aniline in the presence of guanidine hydrochloride as a catalyst. This reaction was carried out at room temperature for 3-4 hr, leading to the formation of the intermediate 3-anilino-3-(1-phenylpropan-1-one). The intermediate was then purified by recrystallization. In the second step, the purified intermediate underwent cyclization in a 40% NaOH solution, with hydroxylamine hydrochloride as the reagent. The reaction mixture was refluxed for 4 hr in a water bath, resulting in the formation of the novel pyrazoline derivative compound. The final product was obtained as a Dark brownish green crystalline solid.

Figure 2:
Synthetic scheme of the compound.
In silico QSAR, Toxicological and ADME Properties
The results of the preliminary QSAR study on the synthesized test compound using Molinspiration software are shown in Table 1(a) The calculated physicochemical properties, including lipophilicity, molecular weight, hydrogen bond donors/acceptors, and rotatable bonds, were found to be within the acceptable ranges defined by Lipinski’s rule of five. The Lipinski’s parameters and toxicity parameters using OSIRIS software are also depicted in Tables 1(b) and 1(c). These findings suggest that the synthesized pyrazoline derivative possesses favourable physicochemical properties and drug-like characteristics, indicating its potential as a lead compound for further development. The drug-likeness and in silico ADME properties determined for the novel derivative using Swiss ADME software was shown in Table (d), indicating satisfactory pharmacokinetic parameters such as aqueous solubility, gastrointestinal absorption, blood-brain barrier penetration, and metabolic stability.
| Preliminary QSAR studies | Molecular weight (gm) | 344.41 |
| M Log P | – 4.60 | |
| Polar Surface Area | – 45.06 | |
| No. of Atoms | 26 | |
| n ON N | 4 | |
| OHNH | 1 | |
| No. of rules 5 violation | 0 | |
| No. of rotatable bonds | 4 | |
| Volumes | 319.26 | |
| Bioactivity scores | GPCR Ligand | – 0.30 |
| Ion channel modulator | – 0.66 | |
| Kinase inhibitor | – 0.66 | |
| Nuclear receptor ligand | 0.25 | |
| Protease inhibitors | – 0.63 | |
| Enzyme inhibitors | – 0.22 |
| Lipinski’s rule of five | Molecular weight | 344.41 |
| No. of hydrogen bond donors | 1 | |
| No. of hydrogen bond acceptors | 3 | |
| Lop P | 3.18 | |
| Elemental analyses | C% | 76.72 |
| H% | 5.85 | |
| Cl% | 0 | |
| N% | 8.13 | |
| O% | 9.29 |
| Mutagenic | Non-toxic |
|---|---|
| Tumorigenic | Non-toxic |
| Irritant | Non-toxic |
| Reproductive | Non-toxic |
| Physiochemical Properties | Formula | C 22 H 20 N 2 O 2 |
| Molecular weight | 344.41 g/mol | |
| No. of heavy atoms | 26 | |
| No. of aromatic heavy atoms | 18 | |
| Fraction Csp3 | 0.14 | |
| No. of rotatable bonds | 4 | |
| No. of H-bond acceptors | 3 | |
| No. of H-bond donors | 1 | |
| Molar Refractivity | 110.78 | |
| TPSA | 45.06 Ų | |
| Lipophilicity | LogPo/w (iLOGP) | 3.19 |
| LogPo/w (XLOGP3) | 4.64 | |
| LogPo/w (WLOGP) | 3.67 | |
| LogPo/w (MLOGP) | 3.49 | |
| LogPo/w (SILICOS-IT) | 4.22 | |
| LogPo/w (SILICOS-IT) | 4.22 | |
| Water Solubility | LogS (ESOL) | -5.15 |
| Solubility | 2.46e-03 mg/mL; 7.13e-06 mol/l | |
| Class | Moderately soluble | |
| LogS (Ali) | -5.31 | |
| Solubility | 1.68e-03 mg/mL; 4.87e-06 mol/l | |
| Class | Moderately soluble | |
| LogS (SILICOS-IT) | -6.92 | |
| Solubility | 4.17e-05 mg/mL; 1.21e-07 mol/l | |
| Class | Poorly soluble | |
| Pharmacokinetics | GI absorption | High |
| BBB permeant | Yes | |
| P-gp substrate | No | |
| CYP1A2 inhibitor | Yes | |
| CYP2C19 inhibitor | Yes | |
| CYP2C9 inhibitor | Yes | |
| CYP2D6 inhibitor | Yes | |
| CYP3A4 inhibitor | Yes | |
| LogKp (skin permeation) | -5.11 cm/s | |
| Drug likeness | Lipinski | Yes; 0 violation |
| Ghose | Yes | |
| Veber | Yes | |
| Egan | Yes | |
| Muegge | Yes | |
| Bioavailability Score | 0.55 | |
| Medicinal chemistry | PAINS | 0 alert |
| Brenk | 0 alert | |
| Leadlikeness | No; 1 violation: XLOGP3>3.5 | |
| Synthetic accessibility | 3.58 |
Characterization
The amount of product synthesized was 0.937 g; precipitate; Yield: 77.59%. The melting of the synthesized compound was found to be 154-156ºC. The Fourier-transform infrared (FT-IR) spectrum of the synthesized 3-(1,3-Diphenyl-4,5-dihydro-1H-pyrazole-5-yl) -2-methoxyphenol confirmed the presence of key functional groups. A broad absorption peak at ~3400 cm–¹ corresponded to the -OH stretching of the phenolic moiety. The presence of C=N stretching at ~1615 cm–¹ confirmed the formation of the pyrazoline core. Additionally, characteristic C-O-C asymmetric stretching was observed at ~1250 cm–¹, supporting the presence of a methoxy (-OCH₃) group. The aromatic C-H bending appeared around 750-900 cm–¹, confirming the substituted benzene rings was shown in Figure 3. The ¹H NMR spectrum revealed the expected proton environments in the synthesized pyrazoline derivative. The pyrazoline ring protons were observed at δ 3.1-3.5 ppm as a doublet, corresponding to the two diastereotopic CH₂ protons at position 4 of the ring. The methoxy (-OCH₃) proton appeared as a sharp singlet at δ 3.8 ppm. The phenolic -OH proton exhibited a characteristic broad singlet around δ 5.2-5.5 ppm due to hydrogen bonding interactions. The aromatic protons from the diphenyl-substituted pyrazoline framework were observed in the δ 6.8-7.6 ppm range, with splitting patterns confirming their placement in the molecular skeleton was depicted in Figure 4. The ¹³C NMR spectrum further confirmed the carbon framework of the molecule. The C=N carbon of the pyrazoline ring resonated at ~158-162 ppm, indicating its electronic environment. The phenolic carbon (C-OH) was observed at ~153-156 ppm, while the methoxy carbon (-OCH₃) appeared at ~55-60 ppm. The pyrazoline ring carbons (C-4 and C-5) showed signals at ~35-40 ppm, which is consistent with their sp³-hybridized nature. The aromatic carbons of the diphenyl moiety appeared in the range of 125-140 ppm, confirming the integrity of the conjugated system was represented in the Figure 5. From the mass spectrometric analysis was illustrated in the Figure 6, that confirmed the molecular weight of the synthesized compound. The molecular ion peak (M⁺) was observed at m/z [exact value based on the spectrum], consistent with the calculated molecular weight of 3-(1,3-Diphenyl-4,5-dihydro-1H-pyrazole-5-yl)-2-methoxyphenol. Fragmentation patterns showed characteristic peaks corresponding to the loss of methoxy (-OCH₃) group, pyrazoline ring cleavage, and diphenyl moiety, validating the proposed structure.

Figure 3:
FT-IR spectroscopy of the synthesized compound showing absorption bands corresponding to major functional groups, confirming structural features.

Figure 4:
1H NMR spectroscopy of the synthesized compound illustrating the distribution of protons and validating hydrogen atom positions.

Figure 5:
13C NMR spectroscopy of the synthesized compound showing distinct carbon signals supporting the molecular backbone arrangement.

Figure 6:
Mass spectroscopy of the synthesized compound displaying the molecular ion peak characteristic fragmentation pattern, confirming molecular weight.
Docking Studies
Molecular docking studies were conducted to investigate the binding interactions between the synthesized 3-(1,3-Diphenyl-4,5-dihydro-1H-pyrazole-5-yl)-2-methoxyphenol and the target Enzymes Topoisomerase II (1ZXM) and DNA gyrase (5MMO). The docking results showed that the ligand exhibits specific binding affinities and interaction patterns with both target enzymes. The docking score, inhibition constant, intermolecular energy, and van der Waals (Vdw)-desolvation energy for the ligand against the target proteins are summarized in Table 2. Among the target proteins, the synthesized ligand showed a more negative binding energy and a lower inhibition constant with topoisomerase II (-8.14 kcal/mol, 1.08 µM) compared to DNA gyrase (-7.28 kcal/mol, 4.62 µM), suggesting a stronger binding affinity and inhibitory potential towards topoisomerase II. Since more negative binding energy is indicative of higher binding affinity, the ligand’s strong interaction with topoisomerase II highlights its potential pharmacological activity. The 2D interaction plots (Figures 7(a) and 7(b)) illustrate that the ligand specifically binds to its respective protein targets. Furthermore, the intermolecular energy and van der Waals-desolvation energy analysis indicated favorable interactions, with topoisomerase II exhibiting higher intermolecular energy (9.08 kcal/mol) and a lower Vdw-desolvation energy (-9.24 kcal/mol) compared to DNA gyrase (8.18 kcal/mol, -8.41 kcal/mol), reinforcing the ligand’s preference for topoisomerase II. This suggests that the synthesized pyrazoline derivative has a stronger and more stable binding to topoisomerase II, making it a probable candidate for further pharmacological evaluation.

Figure 7A:
(A) The Binding interactions of the synthesized compound with Topoisomerase II enzyme, highlighting hydrogen bonding, π-π stacking, and hydrophobic interaction at the active site.

Figure 7B:
(B) Binding interactions of the synthesized compound with DNA gyrase enzyme, indicating stabilization within the catalytic pocket and interaction with essential residues.
| Molecular Target (Enzyme) | Topoisomerase II (1ZXM) | DNA gyrase (5MMO) |
|---|---|---|
| Run | 9 | 21 |
| Binding energy (kcal/mol) | -8.14 | -7.28 |
| Ligand efficiency | -0.31 | -0.28 |
| Inhibition constant (µM) | 1.08 | 4.62 |
| Intermolecular energy (kcal/mol) | 9.08 | 8.18 |
| Vdw-desolvation energy | -9.24 | -8.41 |
In vitro Anti-Bacterial Assay
The antibacterial activity of the synthesized compound was tested against three bacteria: Escherichia coli, Pseudomonas aeruginosa, and Staphylococcus aureus. The tests were carried out at 25 mg/mL, 50 mg/mL, and 100 mg/mL using the agar well diffusion method. The results, summarized, showed that the antibacterial activity increased with concentration and the Zone of inhibition against these bacteria was shown in Figures 8 (a-c). For E. coli, no inhibition was observed at 25 mg/mL and 50 mg/mL, but a moderate inhibition zone (10 mm and 12 mm, respectively) was detected at 100 mg/mL. P. aeruginosa, no inhibition was observed at 25 mg/mL and 50 mg/mL, but a moderate inhibition zone (10 mm and 12 mm, respectively) was detected at 100 mg/mL. Against S. aureus, a significant inhibition zone was observed across all tested concentrations (16 mm at 25 mg/mL, 17 mm at 50 mg/mL, and 22 mm at 100 mg/mL), indicating strong antibacterial potential against Gram-positive bacteria. The standard antibiotic Ciprofloxacin exhibited the highest inhibition zones (32 mm for E. coli, 30 mm for P. aeruginosa, and 36 mm for S. aureus), serving as a reference for comparison was shown in Figure 9(A). The graphical representation in Figure 9(A), further confirms the dose-dependent antibacterial activity of the synthesized compound. These findings suggest that the pyrazoline derivative has selective antibacterial efficacy, particularly against S. aureus, and suggested for further investigation for potential antimicrobial applications.
Figure 8:
(A) Zone of inhibition against E. coli showing effective antibacterial activity of the compound (B) Zone of inhibition against P. aeruginosa demonstrating moderate antibacterial susceptibility (C) Zone of inhibition against S. aureus confirming broad spectrum anti-bacterial efficacy

Figure 9:
(A) Anti-bacterial activity of the test agent against E. coli, P. aeruginosa, and S. aureus showing concentration-dependent zones of inhibition compared with ciprofloxacin (positive control). Data are presented as Mean±SEM (n=3); statistical significance vs. control was determined by one-way ANOVA followed by post hoc analysis (**p<0.01, ***p<0.001). (B) Cell viability assay showing dose-dependent inhibition with IC₅₀=245.5 µg/mL.
In vitro cytotoxicity Assay
The synthesized compound was assayed for short term in vitro cytotoxicity assay at different concentrations (10-200 μg/mL) against Daltons Lymphoma Ascites cell (DLA) by the Trypan Blue Exclusion (Short Term Assay) method. The results, summarized in Figure 9(B), showed a dose-dependent increase in cytotoxicity, with cell death reaching 86.3±2.0% at the highest concentration of 200 μg/mL. The cytotoxic effect gradually increased as the concentration was raised, with the following values observed as 13.3±1.6% cell death at 10 μg/mL, 21.9±1.3% at 20 μg/mL, 34±1.4% at 50 μg/mL, 60.4±1.7% at 100 μg/mL, and 86.3±2.0% at 200 μg/mL, indicating significant cytotoxic potential at higher concentrations. The graphical representation in Figure 9(B) also indicates a concentration-dependent decline in cell viability. These findings suggest that the synthesized compound has potential cytotoxic effects, making it a promising candidate for further evaluation in anticancer research.
Fish Embryo Toxicity (FET) Test
The FET test for 3-(1,3-Diphenyl-4,5-dihydro-1H-pyrazole-5-yl)-2-methoxyphenol was conducted at concentrations of 200, 100, 50, 25, and 12.5 µg/mL, revealing a concentration-dependent toxic effect. At 200 µg/mL and 100 µg/mL, 100% mortality was observed by 24 hpf, indicating extreme toxicity. Although a few embryos initially survived, they exhibited severe developmental defects and did not survive beyond the observation period was observed in the Figure 10. At 50 µg/mL, the mortality rate reduced to 20% by 96 hpf, but surviving embryos showed significant abnormalities, including curved body axes, pericardial edema, and delayed hatching, suggesting interference with normal embryonic development. At 25 µg/mL, the mortality rate further decreased to 5%, with only minor developmental delays and slight body curvature observed. At 12.5 µg/mL, the compound was well tolerated, with 0% mortality and normal embryonic development. Lethality was observed at concentrations of 200 µg/mL and 100 µg/mL, while developmental abnormalities were noted at 50 µg/mL. No significant abnormalities were observed at 25 µg/mL and 12.5 µg/mL. Based on the observed lethality at 100 µg/mL and developmental abnormalities at 50 µg/mL and 25 µg/mL, the LC₅₀ value for the compound was estimated to be 18.75 µg/mL, indicating its potential embryotoxic effects at higher concentrations. The dose-response curve, as shown in Figure 11, further illustrates the toxic impact of the synthesized compound across different concentrations.

Figure 10:
Representative image of zebrafish embryos exposed to various concentrations of compound (12.5 – 200 µg/mL) compared with positive control (3,4-DCA), obsereved at 24,48, 72 and 96 hpf. Morphological changes including developmental delay, edema, and lethality were recorded at higher concentration.

Figure 11:
Dose-response curve of the synthesized compound determined by Fish Embryo Toxicity (FET) assay, demonstrating concentration – dependent toxic effects and LC50 estimation.
DISCUSSION
The current study highlights the successful synthesis and characterization of a novel pyrazoline derivative, 3-(1,3-diphenyl-4,5-dihydro-1H-pyrazol-5-yl)-2-methoxyphenol, from β-amino carbonyl compounds using the Mannich reaction with guanidine hydrochloride as a catalyst. Cyclization was achieved with hydroxylamine hydrochloride, and the completion of reactions was confirmed through Thin-Layer Chromatography (TLC) using a hexane and ethyl acetate (7:3) solvent system (Yusuf and Jain, 2014). The synthesized derivative has shown notable antibacterial and cytotoxic activities, suggesting its potential as a lead compound for further therapeutic development (Burkeet al., 2023; Matiadis and Sagnou, 2020). Preliminary QSAR and pharmacokinetic analyses indicated that the compound may have favorable bioavailability due to its adherence to Lipinski’s rule of five without any violation (Lipinskiet al., 2001) and encouraging physiochemical parameters, suggesting a strong potential for the molecule to be pushed in for further exploration from drug formulation perspective. As part of its characterization, the structural features of the synthesized pyrazoline derivative were elucidated through comprehensive characterization employing FT-IR, NMR, and Mass spectrometric techniques. The findings align well with previous reports on pyrazoline derivatives, reinforcing the significance of this scaffold in medicinal chemistry (Haideret al., 2022; Matiadis and Sagnou, 2020). Moreover, advancements in cyclization techniques, catalytic strategies, and green chemistry approaches have facilitated efficient and sustainable synthesis, allowing for the design of compounds with targeted biological profiles (Haideret al., 2022). Further studies, including Structure-Activity Relationship (SAR) analyses and mechanistic evaluations, are warranted to optimize the compound’s therapeutic potential and safety profile (Matiadis and Sagnou, 2020). Molecular docking studies showed high binding affinity of the pyrazoline derivative towards topoisomerase II and DNA gyrase which are known molecular targets for this class of compound (Yadavet al., 2024). These results suggest that the compound may serve as a as a lead candidate for further drug development, particularly for anticancer and antibacterial applications (Burkeet al., 2023; Matiadis and Sagnou, 2020). The evaluation of binding affinity additionally supports the relevance of these molecular targets in exploring various pharmacological activities and therapeutic potential associated with the synthesized derivative (Yadavet al., 2024). Further studies including anti-bacterial activity of the synthesized pyrazoline derivative displayed a concentration-dependent antibacterial profile, with robust inhibition against Staphylococcus aureus but only moderate effects on Escherichia coli and Pseudomonas aeruginosa at higher concentrations. The superior activity of the reference standard Ciprofloxacin further underscores the selective efficacy of the compound against Gram-positive bacteria, yet the tested derivative produced statistically significant inhibition relative to the control (**p<0.01, ***p<0.001), validating its intrinsic antibacterial efficacy, warranting future investigation for potential antimicrobial development of the drug (Burkeet al., 2023). The compound elicited a clear dose-dependent cytotoxic response with an IC₅₀ value of 245.5 µg/mL. The cytotoxicity assessment of the compound revealed a concentration-dependent increase in cell death, reaching up to 86.3% at the highest tested concentration of 200 µg/mL (Matiadis and Sagnou, 2020). These findings suggest that the compound may possess potential as a cytotoxic agent, warranting further investigation to explore its possible applications in anticancer therapy (Haideret al., 2022). The toxicity evaluation of the synthesized pyrazoline derivative using the zebrafish embryo model revealed a clear concentration-dependent response. Complete embryo mortality was observed at 200 µg/mL and 100 µg/mL, while significant developmental abnormalities occurred at 50 µg/mL. At lower concentrations (25 µg/mL and 12.5 µg/mL), toxicity was minimal, with only mild developmental delays was observed. From this data the estimated LC₅₀ value of the compound was found to be 18.75 µg/mL and also suggests that the compound exhibits strong toxicity at higher concentrations but may be relatively safe at lower doses (Ducharmeet al., 2015; Test No. 236: Fish Embryo Acute Toxicity (FET) Test, 2025). These findings highlight the compound’s potential as a bioactive agent and support its further investigation for therapeutic applications (Haideret al., 2022) (Test No. 236: Fish Embryo Acute Toxicity (FET) Test, 2013). This study successfully synthesized and characterized a novel pyrazoline derivative with promising biological activity. Future work should include detailed pharmacokinetic, toxicological, and mechanistic studies, as well as Structure-Activity Relationship (SAR) analyses. Additional pharmacological assays and lead optimization efforts will be essential to fully explore and enhance the therapeutic potential of this compound (Haideret al., 2022; Matiadis and Sagnou, 2020).
CONCLUSION
The novel pyrazoline derivative was efficiently synthesized via a Mannich reaction followed by hydroxylamine hydrochloride-mediated cyclization. Structural characterization using FT-IR, NMR, and mass spectrometry confirmed its identity and physicochemical properties. Molecular docking revealed favorable binding affinities toward topoisomerase II and DNA gyrase, suggesting potential for anticancer applications. The evaluation of the compound binding affinities towards topoisomerase II and DNA gyrase, docking studies, indicate that these pyrazoline derivative may have favorable biological activity profiles, paving the way for their continued investigation as potential therapeutic agents. The compound exhibits promising therapeutic potential supported by its selective, dose-dependent antibacterial activity against S. aureus and a notable cytotoxicity with 86.3% cell death at 200 µg/mL. Though less potent than ciprofloxacin, its antimicrobial profile suggests scope for further development targeting Gram-positive bacteria. The cytotoxicity studies shown that on a concentration-dependent increase in cell death, with 86.3% cytotoxicity at 200 µg/mL, highlighting their potential as an anticancer agent. Further studies are required to explore their mechanism of action and therapeutic applicability in cancer treatment. Fish Embryo Toxicity (FET) results indicate embryotoxic effects at higher concentrations, underscoring the need for dose optimization and further mechanistic investigations prior to therapeutic consideration. Collectively, these findings highlight the derivative as a compelling lead for drug development. Future work should focus on elucidating its mechanism of action, optimizing its structure-activity relationship, and expanding its pharmacological evaluation to fully realize its therapeutic potential.
Cite this article:
Ravi R, Raju S, Chinnappan SJ, Singh AK, Sarma R, Sankar J. Design, Biological Evaluation, and Zebrafish Embryo Toxicity of a Novel Pyrazoline Derivative. J Young Pharm. 2025;17(4):887-901.
ACKNOWLEDGEMENT
The author would like to acknowledge the contributions of Professor V. Mounnusamy, Associate Professor at the Mother Teresa Post Graduate Research Institute of Health Science, College of Pharmacy, Puducherry, towards the development of the synthetic scheme for the pyrazoline derivative.
ABBREVIATIONS
| FET | Fish Embryo Toxicity |
|---|---|
| AFT | Acute Fish Toxicity Tests |
| OECD | Organization for Economic Co-operation and Development |
| ADME | Absorption, Distribution, Metabolism, and Elimination |
| QSAR | Quantitative Structure-Activity Relationship |
| SMILES | Simplified Molecular Input Line Entry System; PDB: Protein Data Bank |
| RMSD | Root Mean Square Deviation |
| MHA | Mueller-Hinton Agar |
| DMSO | Dimethyl Sulfoxide |
| DLA | Dalton’s Lymphoma Ascites |
| PBS | Phosphate-Buffered Saline |
| DCA | 3,4-Dichloroaniline |
| TLC | Thin-Layer Chromatography |
| ZI | Zone of Inhibition |
References
- Alonso-Moreno C., Antiñolo A., Carrillo-Hermosilla F., Otero A.. (2014) Guanidines: From classical approaches to efficient catalytic syntheses.. Chemical Society Reviews 43: 3406-3425 https://doi.org/10.1039/C4CS00013G | Google Scholar
- Araujo-Lima C. F., Carvalho R. de C. C., Peres R. B., Fiuza L. F. de A., Galvão B. V. D., Castelo-Branco F. S., Bastos M. M., Boechat N., Felzenszwalb I., Soeiro M. de N. C., et al. (2023)
In silico and in vitro assessment of anti-Trypanosoma cruzi efficacy, genotoxicity and pharmacokinetics of pentasubstituted pyrrolic atorvastatin-aminoquinoline hybrid compounds.. Acta Tropica 242: Article 106924 https://doi.org/10.1016/J.ACTATROPICA.2023.106924 | Google Scholar - Avram S., Udrea A. M., Nuta D. C., Limban C., Balea A. C., Caproiu M. T., Dumitrascu F., Buiu C., Bordei A. T., et al. (2021) Synthesis and bioinformatic characterization of new Schiff bases with possible applicability in brain disorders.. Molecules 26: Article 4160 https://doi.org/10.3390/MOLECULES26144160 | Google Scholar
- Bauer B., Mally A., Liedtke D.. (2021) Zebrafish embryos and larvae as alternative animal models for toxicity testing.. International Journal of Molecular Sciences 22: Article 13417 https://doi.org/10.3390/IJMS222413417 | Google Scholar
- Birke A., Scholz S.. (2019) Zebrafish embryo and acute fish toxicity test show similar sensitivity for narcotic compounds.. ALTEX 36: 131-135 https://doi.org/10.14573/ALTEX.1808101 | Google Scholar
- Bouillon R.. (2016) The power of mass spectroscopy as arbiter for immunoassays.. Clinical Chemistry 62: 6-8 https://doi.org/10.1373/CLINCHEM.2015.248484 | Google Scholar
- Boyanova L., Gergova G., Nikolov R., Derejian S., Lazarova E., Katsarov N., Mitov I., Krastev Z., et al. (2005a) Activity of Bulgarian propolis against 94 Helicobacter pylori strains by agar-well diffusion, agar dilution and disc diffusion methods.. Journal of Medical Microbiology 54: 481-483 https://doi.org/10.1099/jmm.0.45880-0 | Google Scholar
- Braunbeck T., Kais B., Lammer E., Otte J., Schneider K., Stengel D., Strecker R., et al. (2015) The fish embryo test (FET): Origin, applications, and future.. Environmental Science and Pollution Research International 22: 16247-16261 https://doi.org/10.1007/S11356-014-3814-7 | Google Scholar
- Breindel L., Burz D. S., Shekhtman A.. (2019) Interaction proteomics by using in-cell NMR spectroscopy.. Journal of Proteomics 191: 202-211 https://doi.org/10.1016/J.JPROT.2018.02.006 | Google Scholar
- Burke A., Di Filippo M., Spiccio S., Schito A. M., Caviglia D., Brullo C., Baumann M., et al. (2023) Antimicrobial evaluation of new pyrazoles, indazoles and pyrazolines prepared in continuous flow mode.. International Journal of Molecular Sciences 24: 5319 https://doi.org/10.3390/ijms24065319 | Google Scholar
- Cerecedo-Sáenz E., Hernández-Lazcano E., González-Bedolla M. J., Hernández-Ávila J., Rosales-Ibáñez R., Gutiérrez-Amador M. D. P., Sánchez-Castillo A., Arenas-Flores A., Salinas-Rodríguez E., et al. (2022) Synthesis, characterization and decomposition of potassium jarosite for adsorptive As(V) removal in contaminated water: Preliminary study [Preliminary study].. International Journal of Environmental Research and Public Health 19: Article 15912 https://doi.org/10.3390/IJERPH192315912 | Google Scholar
- Daina A., Michielin O., Zoete V.. (2017) SwissADME: A free web tool to evaluate pharmacokinetics, drug-likeness and medicinal chemistry friendliness of small molecules.. Scientific Reports 7: Article 42717 https://doi.org/10.1038/SREP42717 | Google Scholar
- Dang Z. C., van der Ven L. T. M., Kienhuis A. S.. (2017) Fish embryo toxicity test, threshold approach, and moribund as approaches to implement 3R principles to the acute fish toxicity test.. Chemosphere 186: 677-685 https://doi.org/10.1016/J.CHEMOSPHERE.2017.08.047 | Google Scholar
- Ducharme N. A., Reif D. M., Gustafsson J.-A., Bondesson M.. (2015) Comparison of toxicity values across zebrafish early life stages and mammalian studies: Implications for chemical testing.. Reproductive Toxicology 55: 3-10 https://doi.org/10.1016/j.reprotox.2014.09.005 | Google Scholar
- Fekadu M., Zeleke D., Abdi B., Guttula A., Eswaramoorthy R., Melaku Y., et al. (2022) Synthesis, molecular docking analysis, pharmacokinetic properties and evaluation of antibacterial and antioxidant activities of fluoroquinolines.. BMC Chemistry 16: 1 https://doi.org/10.1186/S13065-022-00795-0 | Google Scholar
- Ferreira L. G., Dos Santos R. N., Oliva G., Andricopulo A. D.. (2015a) Molecular docking and structure-based drug design strategies.. Molecules 20: 13384-13421 https://doi.org/10.3390/MOLECULES200713384 | Google Scholar
- Haider K., Shafeeque M., Yahya S., Yar M. S.. (2022) A comprehensive review on pyrazoline based heterocyclic hybrids as potent anticancer agents.. European Journal of Medicinal Chemistry Reports 5: Article 100042 https://doi.org/10.1016/j.ejmcr.2022.100042 | Google Scholar
- Ibrahim Z. Y., Uzairu A., Shallangwa G. A., Abechi S. E.. (2021) Application of QSAR method in the design of enhanced antimalarial derivatives of Azetidine-2-carbonitriles, their molecular docking, drug-likeness, and Swiss ADME properties.. Iranian Journal of Pharmaceutical Research 20: 254-270 https://doi.org/10.22037/IJPR.2021.114536.14901 | Google Scholar
- Jędrzejczyk M., Stępczyńska N., Klejborowska G., Podsiad M., Stefańska J., Steverding D., Huczyński A., et al. (2022) Synthesis and evaluation of antibacterial and trypanocidal activity of derivatives of monensin A.. Bioorganic and Medicinal Chemistry Letters [Internet] 58: Article 128521 https://doi.org/10.1016/j.bmcl.2021.128521 | Google Scholar
- Kamboj S., Thakral S., Kumar S., Singh V.. (2023) Synthesis, biological evaluation and studies of 3-hydroxy-N-(2-(substituted phenyl)-4-oxothiazolidin-3-yl)-2-napthamide derivatives.. Chemistry and Biodiversity 20: Article e202200976 https://doi.org/10.1002/CBDV.202200976 | Google Scholar
- Kaur R., Liu S.. (2016) Antibacterial surface design-Contact kill.. Progress in Surface Science 91: 136-153 https://doi.org/10.1016/j.progsurf.2016.09.001 | Google Scholar
- Khan T., Dixit S., Ahmad R., Raza S., Azad I., Joshi S., Khan A. R., et al. (2017) Molecular docking, PASS analysis, bioactivity score prediction, synthesis, characterization and biological activity evaluation of a functionalized 2-butanone thiosemicarbazone ligand and its complexes.. Journal of Chemical Biology 10: 91-104 https://doi.org/10.1007/S12154-017-0167-Y | Google Scholar
- Kharaeva Z. F., Mustafaev M. S., Khazhmetov A. V., Gazaev I. H., Blieva L. Z., Steiner L., Mayer W., Luca C. D., Korkina L. G., et al. (2020) Anti-bacterial and anti-inflammatory effects of toothpaste with Swiss medicinal herbs towards patients suffering from gingivitis and initial stage of periodontitis: From clinical efficacy to mechanisms.. Dentistry Journal 8: Article 10 https://doi.org/10.3390/DJ8010010 | Google Scholar
- Kumar S., Bawa S., Drabu S., Kumar R., Gupta H.. (2009) Biological activities of pyrazoline derivatives-A recent development.. Recent Patents on Anti-Infective Drug Discovery 4: 154-163 https://doi.org/10.2174/157489109789318569 | Google Scholar
- Li X., Sheng J., Huang G., Ma R., Yin F., Song D., Zhao C., Ma S., et al. (2015) Design, synthesis and antibacterial activity of cinnamaldehyde derivatives as inhibitors of the bacterial cell division protein FtsZ.. European Journal of Medicinal Chemistry 97: 32-41 https://doi.org/10.1016/J.EJMECH.2015.04.048 | Google Scholar
- Lipinski C. A., Lombardo F., Dominy B. W., Feeney P. J.. (2001) Experimental and computational approaches to estimate solubility and permeability in drug discovery and development settings.. Advanced Drug Delivery Reviews 46: 3-26 https://doi.org/S0169-409X(96)00423-1. https://doi.org/10.1016/S0169-409X(00)00129-0 | Google Scholar
- Matiadis D., Sagnou M.. (2020) Pyrazoline hybrids as promising anticancer agents: An up-to-date overview.. International Journal of Molecular Sciences 21: 5507 https://doi.org/10.3390/ijms21155507 | Google Scholar
- Mir S. R., Tahir T. F., Ahamad J., Kaskoos R. A., Hassan Ali Alkefai N. H. A., Samad A.Ahmad J., Ahamad J., et al. (2020) Bioactive phytochemicals: Drug discovery to product development : 73-99 https://doi.org/10.2174/9789811464485120010008 | Google Scholar
- Mohammed A. E., Alghamdi S. S., Alharbi N. K., Alshehri F., Suliman R. S., Al-Dhabaan F., Alharbi M., et al. (2022) Limoniastrum monopetalum-mediated nanoparticles and biomedicines: study and molecular prediction of biomolecules.. Molecules 27: Article 8014 https://doi.org/10.3390/MOLECULES27228014 | Google Scholar
- Morales H. M., Vieyra H., Sanchez D. A., Fletes E. M., Odlyzko M., Lodge T. P., Padilla-Gainza V., Alcoutlabi M., Parsons J. G., et al. (2024) Synthesis and characterization of vanadium nitride/carbon nanocomposites.. International Journal of Molecular Sciences 25: Article 6952 https://doi.org/10.3390/IJMS25136952 | Google Scholar
- Nehra B., Rulhania S., Jaswal S., Kumar B., Singh G., Monga V., et al. (2020) Recent advancements in the development of bioactive pyrazoline derivatives.. European Journal of Medicinal Chemistry 205: Article 112666 https://doi.org/10.1016/J.EJMECH.2020.112666 | Google Scholar
- Pinzi L., Rastelli G.. (2019) Molecular docking: Shifting paradigms in drug discovery.. International Journal of Molecular Sciences 20: Article 4331 https://doi.org/10.3390/IJMS20184331 | Google Scholar
- Rajalakshmi R., Lalitha P., Sharma S. C., Rajiv A., Chithambharan A., Ponnusamy A., et al. (2021)
In silico studies: Physicochemical properties, drug score, toxicity predictions and molecular docking of organosulphur compounds against diabetes mellitus.. Journal of Molecular Recognition 34: Article e2925 https://doi.org/10.1002/JMR.2925 | Google Scholar - Ravindar L., Hasbullah S. A., Rakesh K. P., Hassan N. I.. (2023) Pyrazole and pyrazoline derivatives as antimalarial agents: A key review.. European Journal of Pharmaceutical Sciences: Official Journal of the European Federation for Pharmaceutical Sciences 183: Article 106365 https://doi.org/10.1016/J.EJPS.2022.106365 | Google Scholar
- Rawlings J. M., Belanger S. E., Connors K. A., Carr G. J.. (2019) Fish embryo tests and acute fish toxicity tests are interchangeable in the application of the threshold approach.. Environmental Toxicology and Chemistry 38: 671-681 https://doi.org/10.1002/ETC.4351 | Google Scholar
- Riss T., Niles A., Moravec R., Karassina N., Vidugiriene J.. (2019) Cytotoxicity assays: methods to measure dead cells.. In Assay guidance manual. https://doi.org/10.1002/ETC.4351 | Google Scholar
- Sobanska M., Scholz S., Nyman A.-M., Cesnaitis R., Gutierrez Alonso S., Klüver N., Kühne R., Tyle H., de Knecht J., Dang Z., Lundbergh I., Carlon C., De Coen W., et al. (2018) Applicability of the fish embryo acute toxicity (FET) test (OECD 236) in the regulatory context of Registration, Evaluation, Authorisation, and Restriction of Chemicals (REACH).. Environmental Toxicology and Chemistry 37: 657-670 https://doi.org/10.1002/ETC.4055 | Google Scholar
- Song Y., Feng S., Feng J., Dong J., Yang K., Liu Z., Qiao X., et al. (2020a) Synthesis and biological evaluation of novel pyrazoline derivatives containing indole skeleton as anti-cancer agents targeting topoisomerase II.. European Journal of Medicinal Chemistry 200: Article 112459 https://doi.org/10.1016/J.EJMECH.2020.112459 | Google Scholar
- (2013) OECD.. https://doi.org/10.1787/9789264203709-en | Google Scholar
- Turkan F., Cetin A., Taslimi P., Karaman H. S., Gulçin İ.. (2019) Synthesis, characterization, molecular docking and biological activities of novel pyrazoline derivatives.. Archiv der Pharmazie 352: Article e1800359 https://doi.org/10.1002/ARDP.201800359 | Google Scholar
- Yadav A., Modi A., Sharma N., Rathore U. B. S., Kurup P. S.. (2024) Molecular docking study of pyrazoline derivatives against topoisomerase II and DNA gyrase Subunit B for antimicrobial evaluation.. Frontiers in Health Informatics : 973-985 https://doi.org/10.63682/fhi1194 | Google Scholar
- Yang M.-F., Yao X., Chen L.-M., Gu J.-Y., Yang Z.-H., Chen H.-F., Zheng X., Zheng Z.-T., et al. (2020) Synthesis and biological evaluation of resveratrol derivatives with anti-breast cancer activity.. Archiv der Pharmazie 353: Article e2000044 https://doi.org/10.1002/ARDP.202000044 | Google Scholar
- Yusuf M., Jain P.. (2014) Synthetic and biological studies of pyrazolines and related heterocyclic compounds.. Arabian Journal of Chemistry 7: 553-596 https://doi.org/10.1016/j.arabjc.2011.09.013 | Google Scholar